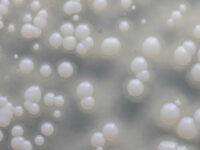
Bètaglucaan ondersteunt bij pollenallergie

Een recente studie toont aan dat voeding met een lage omega-3- en -omega-6- vetzuurratio gecombineerd met visoliesupplementen, de groei van prostaatkankercellen significant vermindert. Het ging om de CAPFISH-3 klinische trial van het UCLA Health Jonsson Comprehensive Cancer Center. De onderzoekers wezen 100 mannen met een laag- of gemiddeld risico op prostaatkanker die kozen voor actieve…
Lees meer
Lees meer